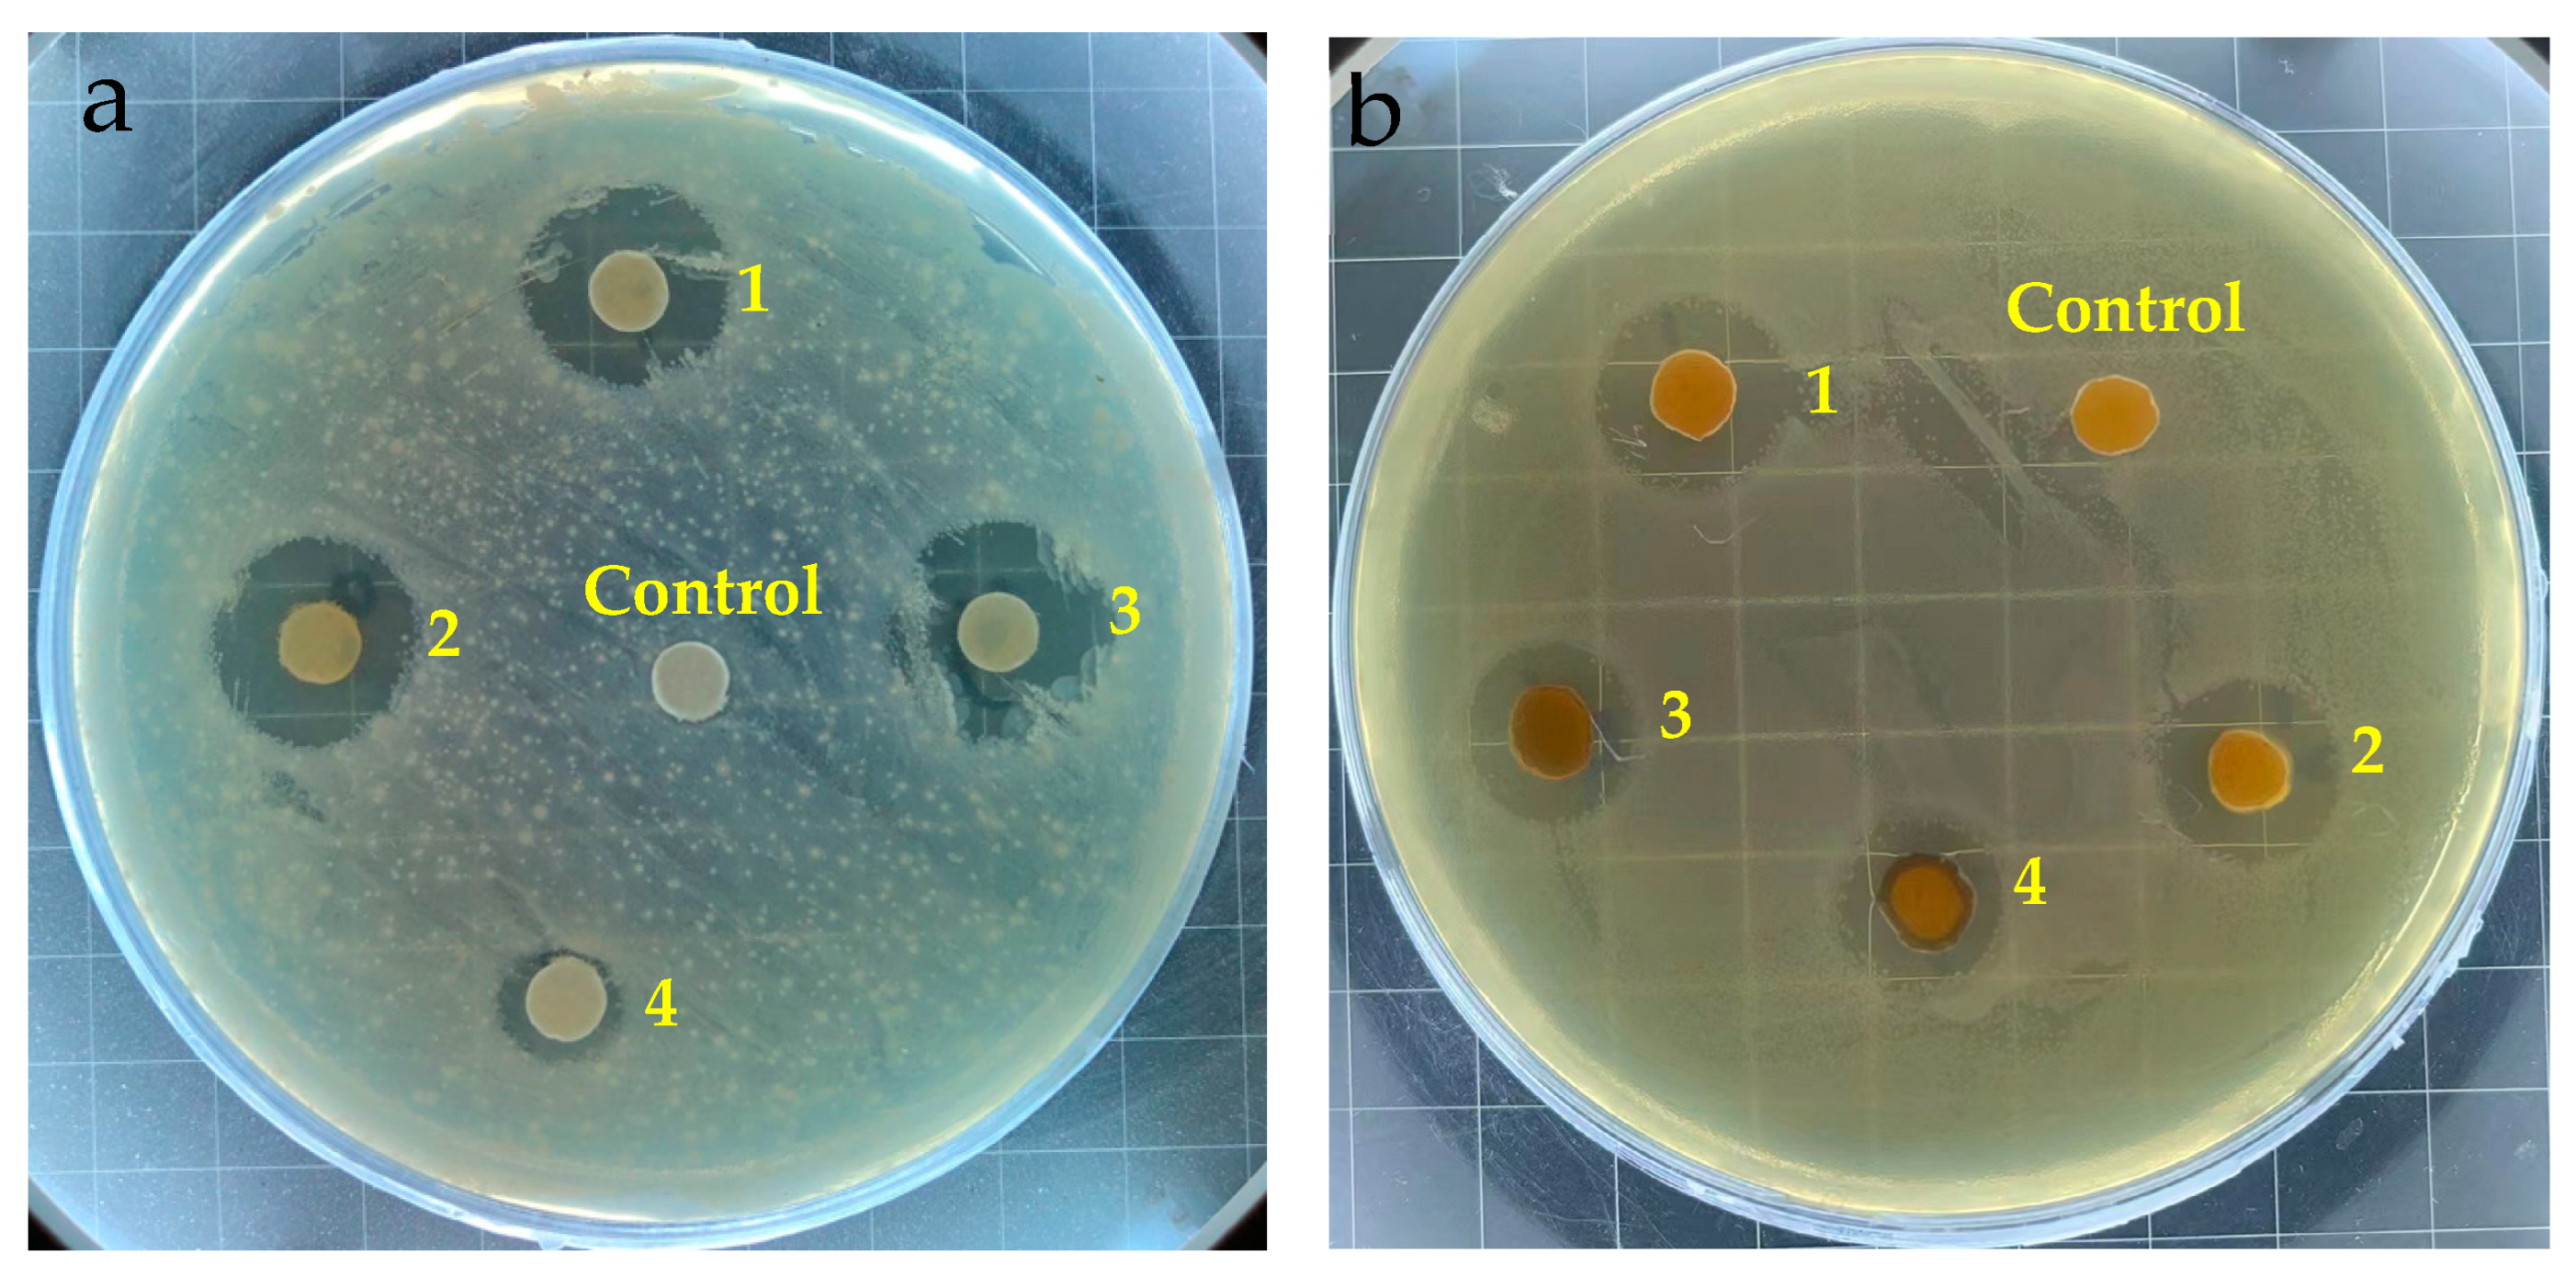
Coatings 14 00297 g004

1. Introduction
Biological contamination poses a continuous health risk, as surfaces often serve as a medium for bacteria and other microorganisms, enabling their rapid reproduction and transmission. Microorganisms can survive on inanimate surfaces for hours, days, and weeks, or even longer. For instance, the COVID-19 coronavirus had a half-life of 18 h at a temperature of 21–24 °C and a relative humidity of 20% [
1]. Disease transmission occurs significantly through surface contact between individuals, between animals and humans, and between animals themselves. Conventional protective and decorative coatings lack antibacterial properties, making these surfaces not only potential transmission vectors for pathogens but also susceptible to mold infestation [
2]. This poses a significant challenge for coatings containing high levels of organic compounds. Therefore, antibacterial coatings which can kill the bacteria and viruses on the surfaces of objects are of great importance in preventing the indirect transmission of pathogenic microorganisms. Existing regular coatings mainly comprise solvent coatings, aqueous coatings, powder coatings, etc. Compared to solvent coatings, which cause the emission of VOCs, increasing research attention has been focusing on the production of environmentally friendly powder coatings which have the advantages of being VOC-free, low-cost, and high-efficiency, with a high recovery rate of 98% [
3]. Powder coatings generally contain resin, a curing agent, a filler, pigment, and other additives. These gradients are mixed, extruded into chips, and ground into coating powders, which are then electrostatically sprayed onto the substrate and cured upon heating, forming a durable coating film. Due to the advantages of powder coatings, functional antimicrobial powder coatings have become an important research direction in the coating industry [
4].
Antimicrobial powder coatings are fabricated by adding antimicrobial agents into coatings to realize a sterilization ability. In comparison with other antimicrobial heavy metals, silver is considered to be an exceptionally promising antibacterial material for use in coating systems because it offers numerous advantages, i.e., safety, broad-spectrum efficacy, long-lasting effects, and significant inhibition [
5]. The WHO and US EPA have concluded that silver levels of 0.1 mg/L are tolerable in drinking water, and the EFSA (European Food Safety Agency) recommends thresholds of 0.05 mg/L in water and 0.05 mg/kg in food [
6]. The concentration of silver which allows for antimicrobial activity can be as low as 10
−4 mg/L; this is well below the threshold values, indicating the safety of applications involving silver [
7,
8,
9]. It is generally believed that positively charged silver metal ions can effectively bind to the surface of bacterial cell membranes, facilitated by electrostatic attraction; subsequently, they penetrate the cell wall, causing it to rupture and leading to the release of cellular contents, ultimately resulting in bacterial death [
10,
11]. Silver ions are generally loaded onto carrier materials and then introduced to coating systems. Carrier materials should have some important parameters, including unique characteristics in cation exchange capacity and pore structure, as these aspects influence the function of the active components. It is widely reported that zeolite- and clay-based materials can serve as carriers for silver ions [
12,
13,
14]. Zeolite carriers possess a framework of silicate with high adsorption and ion exchange capabilities, which permits them to act as inorganic reservoirs for silver ions [
15,
16,
17,
18]. N. Torkian et al. employed modified zeolite as a silver ion carrier to produce a Ag-ion-exchanged nanocomposite and successfully applied it in antibacterial applications [
18]. Clay-like carriers have a layered silicate structure that can hold cations to maintain electrical neutrality and an abundant interlayer pore structure for the accommodation of silver ions or other cations [
19,
20,
21]. In addition, they also have the advantages of natural abundance and cost effectiveness, a non-toxic nature, and chemical inertness [
22]. In the study by W. Guo et al., silver was loaded into the interlayer space of montmorillonite, which endowed the PGA scaffold with sustained Ag
+ release and long-lasting antibacterial properties [
23].
These materials have been well reported as silver ion carriers, and most studies have generally adopted one or one-type carrier material; for example, Cerrillo et al. applied zeolite in the preparation of antimicrobial agents [
12], and Malachová used montmorillonites as active ion carriers [
24]. However, the effect of different types of carriers on silver antimicrobial activity and stability in coating systems, especially in powder coatings, is rarely studied. The curing of powder coatings requires high-temperature treatment, which can reach a maximum of 200 °C [
25]. Under this extreme-heat condition, silver ions are susceptible to reduction, forming yellow metallic silver particles, which leads to yellowing of the coating surface; this decreases the aesthetic appearance and also deactivates the active silver, decreasing the antimicrobial activity. Carrier materials can provide a protective effect for silver ions; the geometric properties and the binding affinity of carriers to silver may vary. To investigate their influence on silver activity and stability as well as the coating properties, two widely used zeolite materials (Linde type A and Y-type) and two clay-based materials (montmorillonite and vermiculite) were utilized to produce ion-exchange antimicrobial agents and their antimicrobial effectiveness in powder coatings was evaluated. The protection of carriers on Ag
+ was also investigated via a color difference test, considering the tendency for Ag
+ oxidation to occur under the high-temperature condition during powder coating production and curing.
3. Results and Discussion
3.1. Analysis of Antibacterial Agents and Carriers
Table 1 presents the cation exchange capacity, specific surface area, pore volume, and average pore size of the four carriers. The table reveals that zeolite carriers possess a higher ion exchange capacity compared to clay-based carriers, attributed to their low silicon–aluminum ratio and higher aluminum content, which requires more cations for charge balance. There are a large number of exchangeable cations in the internal space. The LTA zeolite exhibits a lower Si/Al ratio than the Y-type zeolite, resulting in a higher exchange capacity. On the other hand, montmorillonite carriers only have exchangeable cations between their layers, which are limited in number.
In terms of surface area, zeolite carriers have a larger surface area than clay-based carriers. This is due to their refined and intricate structure, featuring more nanopores and a greater internal surface area, as well as smaller particle sizes. While there is not a noticeable difference in pore volume, zeolite carriers tend to have a slightly larger volume than clay-based carriers. The most significant distinction lies in the average pore size. Zeolite sieve carriers possess significantly smaller pore sizes than clay-based materials, which is attributed to their structure. The pore channels of zeolite are typically the size of the minimum diameter of the α-cage, whereas the pore size of clay-based carriers corresponds to the interlayer domain distances, which are considerably larger than the α-cage diameter of zeolite.
Figure 1 shows the SEM images of four types of carriers, indicating the presence of layered structures on the surface morphologies of montmorillonite and vermiculite. Among them, the particles of montmorillonite are relatively small, ranging from approximately 20 to 30 μm. A fine layered structure with a large number of mesopores and macropores on the surface can be seen. The layered structure of vermiculite has large voids, with single-layered stacking to form a thicker structure, making it a typical layered silicate. Vermiculite particles are larger and have a wide particle size distribution, with a medium particle size of approximately 70 μm. Most particles do not produce thicker layers. Due to the large size of vermiculite particles, grinding was carried out to decrease the medium size to 30 μm before ion exchange. Both Y-type and LTA Zeolite carriers exhibit regular geometric shapes of small squares with a particle size between 1 and 5 μm. The particle size would have a large impact on their distribution on coatings and the final coating properties.
The silver distribution and content were characterized by SEM-EDS mapping and ICP testing, as shown in
Figure 2 and
Table 2. The silver content in the antibacterial agents is in the order of Ag-LTA > Ag-Y > Ag-M > Ag-V, which is consistent with the carriers’ CEC results. As seen from the EDS mapping, silver is uniformly distributed on the carriers. The zeolite materials have better silver-accommodation ability compared to clay-based carriers.
3.2. Antibacterial Properties of Antibacterial Agents
To evaluate the antimicrobial efficacy of various antimicrobial agents, their minimum inhibitory concentrations (MICs) were determined. The antimicrobial agents were added to bacterial suspensions with initial concentrations of approximately 105 CFU/mL, and the absorbance was measured over time. This quantitative assessment method enables the rapid evaluation of antimicrobial activity.
Figure 3 clearly demonstrates that all tested antimicrobial agents had an impact on the growth kinetics of
E. coli compared to the control group. As the concentration of the antimicrobial agent increased, the inhibitory effect on bacterial growth intensified. The Ag-LTA antimicrobial agent, for instance, achieved complete inhibition at a concentration of 150 μg/mL, while the corresponding concentrations for Ag-Y, Ag-M, and Ag-V were 250 μg/mL, 400 μg/mL, and 600 μg/mL, respectively (
Table 3). It is worth noting that Ag-LTA exhibited the strongest antimicrobial activity against
E. coli, requiring the lowest concentration among the tested agents to inhibit bacterial growth. Consequently, the addition of the Ag-LTA zeolite antimicrobial agent in practical applications would necessitate a smaller dosage, minimizing its impact on powder coating layers. As the antimicrobial agent concentrations increased from 0 to 70 μg/mL, the absorbance reductions within 24 h were 32.6 %, 16.5 %, 3.2 %, and 2.7 % for the respective antimicrobial agents. These results highlight the rapid antimicrobial rate and high effectiveness of the additives with the zeolite carrier; in contrast, clay-based materials exhibited lower antimicrobial activity due to their inferior ion exchange capacity. These results are consistent with the silver content of the carriers.
The results of the antibacterial ring inhibition tests for the four types of antibacterial agents are shown in
Figure 4. Among the suspension test groups, the control group shows a minimal–absent inhibition ring, while the Ag-LTA, Ag-Y, and Ag-M antimicrobial agents exhibit significant antibacterial effects. The Ag-V antimicrobial agent displayed a weaker effect, suggesting a limited diffusion capability of its silver ions on solid culture media. Despite having a lower silver content, the Ag-M antimicrobial agent demonstrated comparable antibacterial activity to the zeolite antimicrobial agents, owing to its strong diffusion capacity. Zeolite antimicrobial agents, characterized by predominantly microporous channels, facilitate ion exchange rather than diffusion within the channels, making the diffusion of silver ions relatively facile. Moreover, the larger particle size of vermiculite results in fewer antibacterial particles being immersed during the preparation of the antimicrobial disk, thereby influencing its antibacterial efficacy in the disk experiment. The trend of antibacterial activity tested with pellets was similar to that in the suspension test, but the difference is not exactly the same. Vermiculite shows higher antimicrobial activity when eliminating the size effect on the particle loading amount in the suspension test. To investigate the antimicrobial activities of the carriers, zeolite LTA was used for comparison, and we can see from
Figure 4b that the carrier material shows no antimicrobial ability. Similarly, none of the other carriers show any sterilization capacity (pictures not shown).
3.3. Antibacterial Properties of Coatings
The MIC and antibacterial ring inhibition tests indicated the high activities of the antimicrobial agents. However, they cannot directly reflect the coating properties, since the agents are bound in the coating matrix instead of being in a free state, so the antimicrobial activity of coatings was evaluated. The continuous and controlled release of active silver ions from the coating surface to the pathogenic environment is a critical factor for the effectiveness of antimicrobial products. The antimicrobial efficacy relies on the concentration of silver ions, which, in turn, is primarily influenced by the ion strength of the medium.
Figure 5 illustrates the antimicrobial properties of the coated plates under consistent medium-ion-strength conditions. The test solution containing a 0.85 wt% NaCl solution enables the sodium ions to serve as environmental ions that replace silver ions on the carriers through ion exchange, facilitating the release of silver ions into the surrounding environment. Most body fluids, e.g., sweat, contain sodium or other cations, so this test mimics real-world human contact with the coatings. In hospitals or other public areas, when sweaty hands or other body parts make contact with contaminated surfaces, the cations in the body fluid would activate the antimicrobial coatings. The thickness of all the coating films was maintained at 55−65 μm for consistency. To eliminate the possibility that the antimicrobial effect was a result of the carriers themselves, antimicrobial tests were also conducted on coatings with pure carrier agents. The results show no antimicrobial activity was present for any of the four carriers. In addition, all the antimicrobial tests on silver agents were conducted three times, and the standard deviation was within 1% for each agent (the error bars are too small to be seen for some data points), indicating consistent and stable activity.
Compared with commercial agents, all the antibacterial agents present higher antibacterial activities with reduction rates of over 99% (
Table 4). It can be seen in
Figure S2 that the No. of
E. coli is dramatically reduced after treatment with the antimicrobial coatings. Among the four agents, the Ag-LTA zeolite antimicrobial agent exhibited rapid bactericidal effects. Within the first 6 h, it showed the steepest decline in bacterial count, indicating strong antimicrobial efficacy within a short period. Moreover, the Ag-LTA coatings withstand seven washing cycles, indicating great durability (
Figure 6). Comparatively, the antimicrobial activity of the Ag-Y antimicrobial agent is initially weaker than that of Ag-LTA, but the bacterial count reaches a similar level after 24 h, suggesting comparable long-term effectiveness. On the other hand, Ag-M antimicrobial plates exhibit similar initial antimicrobial effects to Ag-Y, but the bacterial count remains higher after 24 h, resulting in slightly inferior efficacy. Nonetheless, there is still a three-order-of-magnitude reduction in bacterial count, achieving a sterilization efficiency that exceeds 99.9 %. In contrast, the Ag-V antimicrobial plates show relatively poor sterilization efficacy, with only a one-order-of-magnitude decrease in bacterial count within 24 h; however, it still achieved a sterilization rate that exceeded 99 % compared to the control group. Zeolite antimicrobial agents, characterized by their large exchangeable ion capacity and abundance of silver ions, also have a high surface area, a small particle size, and a high water absorption capacity. These characteristics lead to uniform dispersion in coatings and an increased rate for the ion exchange process, resulting in higher silver ion release and improved antimicrobial performance. Similarly, clay-based antimicrobial agents also possess strong water absorption capacity, promoting the release of silver ions.
The leaching test of Ag+ from antimicrobial coatings showed that the concentration of leaching Ag+ in the solution is 0.026 mg/L, which is lower than the tolerance of releasing silver (under 0.1 mg/L) in drinking water that is recommended by the World Health Organization (WHO) and the US EPA. Therefore, the application of silver ions in this powder coating system has no safety issues.
3.4. Properties of the Antibacterial Coatings
The color of the coating surface is a crucial parameter that indicates the state of the silver within the coating. When silver ions undergo a reduction to nano silver, the coating color changes to yellow, which significantly impacts the overall appearance of the coating. The reduction of silver ions to metallic silver leads to a more significant yellowish color difference [
31]. This is also verified by the XPS spectrum of the Ag 3d region (
Figure S3) for the Ag-LTA agent. The peak positions of Ag 3d
3/2 and Ag 3d
5/2 were 374.0 and 367.8 eV, respectively. The peak center of Ag 3d
5/2 is located between 368.2 eV (corresponding to Ag
0) and 367.4 eV (corresponding to Ag
+); this indicates the coexistence of silver ions and elemental silver [
23,
32]. Ideally, it is desirable for the silver on the coating surface to exist in the form of ions, enabling it to promptly engage in combating microorganisms when necessary.
Table 5 presents the color difference results of the four antimicrobial coatings compared to the control group without antimicrobial additives. The color difference parameters measured include ΔE, ΔL, Δb, and Δa.
Figure 7 provides visual representations of the coatings containing the four antibacterial additives. Upon the addition of antimicrobial agents, the color of the coatings undergoes varying degrees of change. Notably, the Δb value indicates the most significant shift towards a yellow color. This can be attributed to the high reduction potential of silver ions, which makes them prone to reduction during the high-temperature curing process that is necessary for the coating. Consequently, fine silver particles are formed and adhere to the surface, imparting a distinct yellow hue to the coating.
Among the different carriers, the extent of yellowing caused by the Ag-LTA antimicrobial agent is the lowest. This can be attributed to the restricted formation of elemental silver within the confined interior space of the α-cage structure, providing protection to the silver ions. In contrast, montmorillonite and vermiculite carriers with larger internal spaces, such as mesoporous and macroporous spaces, exhibit more pronounced yellowing. Furthermore, clay-based carriers with larger pore sizes facilitate the detachment of silver ions from the carrier, leading to their reduction in response to the external environment.
The morphologies of antibacterial coatings are exhibited in
Figure S4. Agents with silver ions can be clearly seen on the coating surface except the coating with Ag-V, which is with the lowest silver loading. The mechanical properties were characterized by impact resistance, hardness, and adhesive strength tests, as shown in
Table 5. Compared to the control sample, the antimicrobial coatings with different agents present the same high impact resistance, hardness, and adhesive strength. The introduction of agents does not damage the coating structure and properties.
4. Conclusions
In this paper, we investigated the antimicrobial properties and application of silver ion antimicrobial agents with different carriers in powder coatings. Each carrier has its unique characteristics, and their effect on antimicrobial efficacy varies due to differences in cation exchange capacity and pore size. Among them, the Ag-LTA zeolite antimicrobial agent demonstrates the highest effectiveness. The LTA zeolite not only has a high surface area, a small particle size, and a high silver content, but also provides a protection effect to silver ions, since the confined spaces within the sieve restrict the reduction of silver ions to some extent. The Y-type zeolite antimicrobial agent exhibits good antimicrobial performance. However, its high silicon–aluminum ratio and low cation exchange capacity result in lower silver loading efficiency. Additionally, the larger pore size of the Y-type zeolite makes the silver ions more susceptible to detachment from the carrier. In the presence of external environmental influences, they are more prone to reduction, leading to significant yellowing of the coating film. Antimicrobial agents utilizing clay-based carriers have even lower cation exchange capacity, resulting in poorer antimicrobial effectiveness. The Ag-V antimicrobial agent, for instance, achieves the lowest reduction rate after 24 h. The larger particle size of montmorillonite and vermiculite significantly impacts the appearance of the coating film, causing it to darken. Moreover, due to their larger pore size, silver ions readily detach from these carriers and undergo reduction reactions in the external environment. The degree of yellowing in the coating is consequently larger compared to the coatings with zeolite-type carriers. This paper studied the effect of zeolite- and clay-based carriers on the properties of Ag antimicrobial agents in the green powder coating system and provides guidance for the fabrication of active antimicrobial agents and coatings. It is noted that color changes for coating samples with different carrier materials are all relatively large; therefore, the questions of how to protect silver ions from reduction and how to maintain the high quality of the coatings are also worth studying. Additionally, strategies to improve the antimicrobial durability either through the control of silver release or recharging the coating with silver ions in some special application scenarios will be studied in future work.